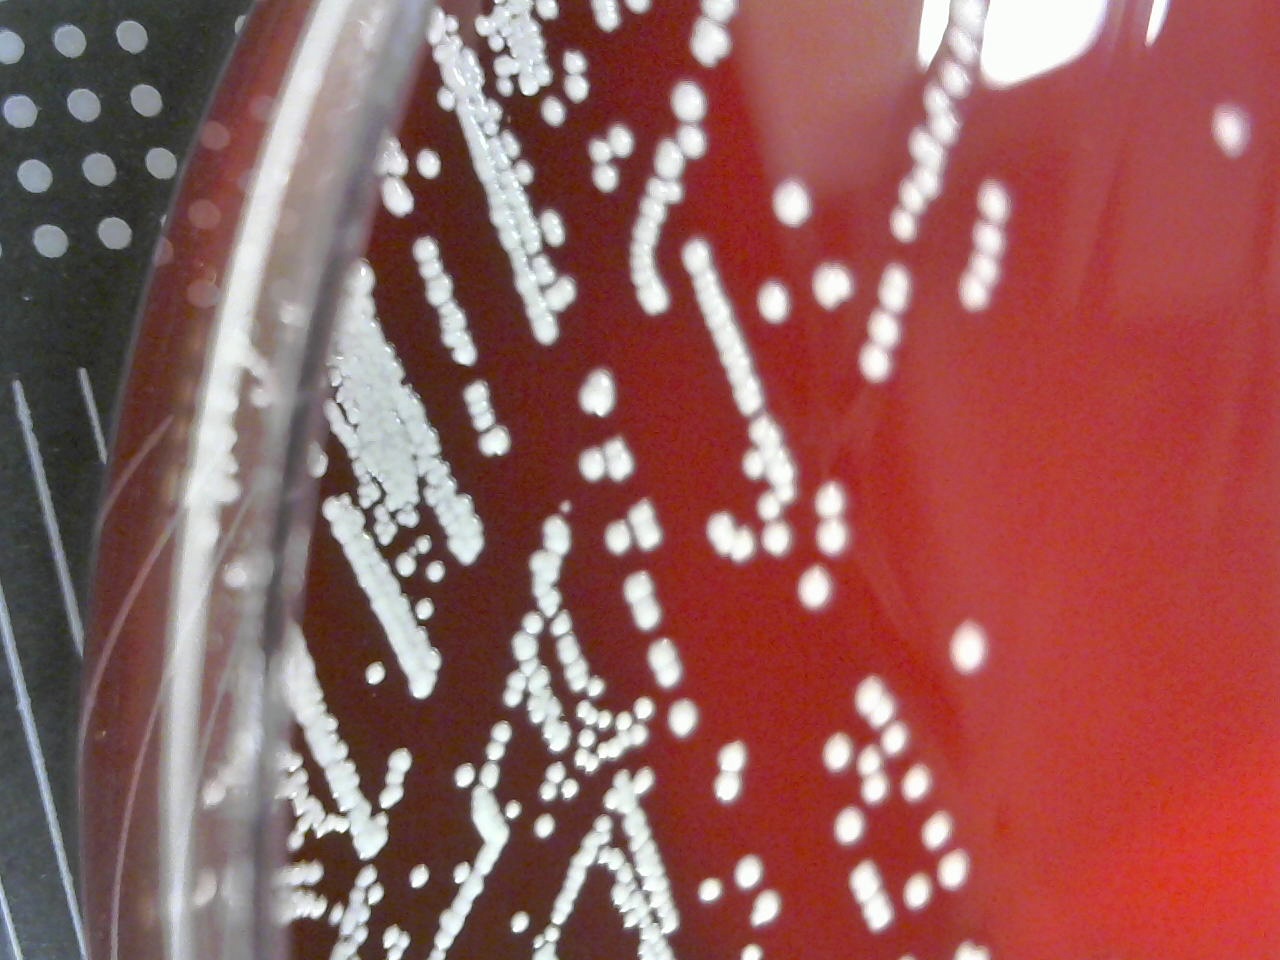
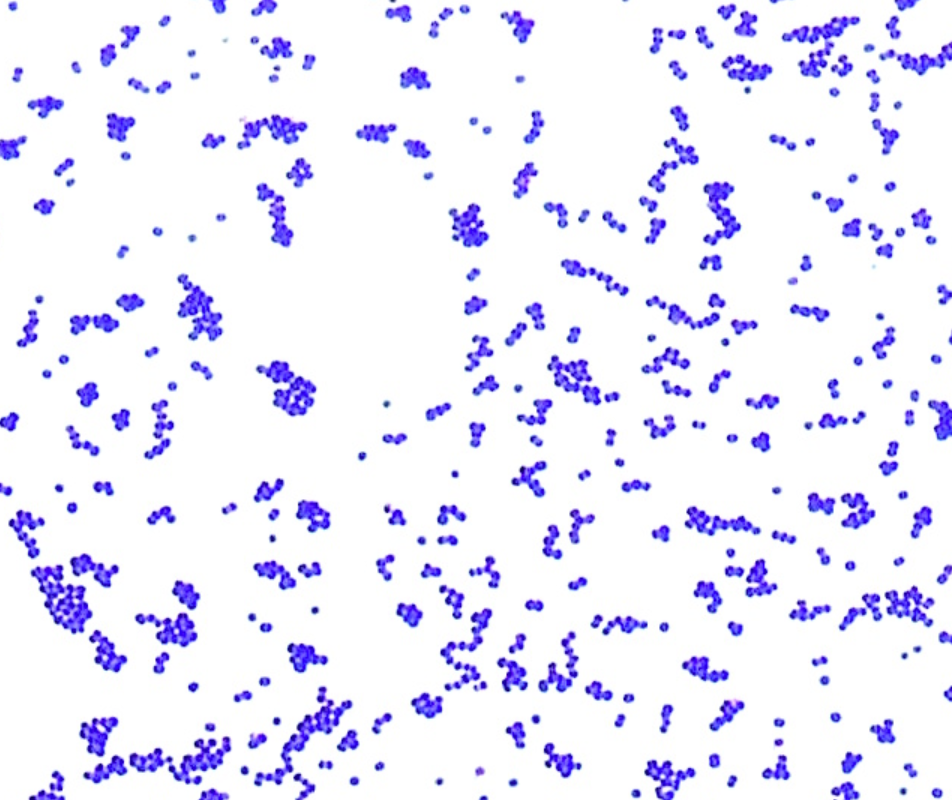

Staphylococcus
Staphylococcus saprophyticus


Incubation: Aerobic
Media: SBA
Source: Urine
Colony Morphology
Form: Round
Elevation: Raised
Margin: Entire
Color: White
Hemolysis — Gamma/None
Gram Stain
Gram Positive
Microscopic Morphology: Cocci
Organism Size: Small
Special Characteristics: Clusters
Testing Pathways
Catalase: Positive
Cogulase (Latex): Negative
Bacitracin Sensitivity: Resistant
PYR: Negative
Novobiocin: Resistant
Staphylococcus epidermidis

Incubation: Aerobic
Media: SBA
Source: Wound
Colony Morphology
Form: Round
Elevation: Raised
Margin: Entire
Color: White
Hemolysis — Gamma/None
Gram Stain
Gram Positive
Microscopic Morphology: Cocci
Organism Size: Medium
Special Characteristics: Clusters
Testing Pathways
Catalase: Positive
Cogulase (Latex): Negative
Bacitracin Sensitivity: Resistant
PYR: Negative
Novobiocin: Sensitive
Staphylococcus aureus


Incubation: Aerobic
Media: SBA
Source: Wound
Colony morphology
Form: Round
Elevation: Raised
Margin: Entire
Color: Yellow/Gold
Hemolysis — Gamma/None
Gram Stain
Gram Positive
Microscopic Morphology: Cocci
Organism Size: Small
Special Characteristics: Clusters
Testing Pathways
Catalase: Positive
Coagulase (Latex): Positive